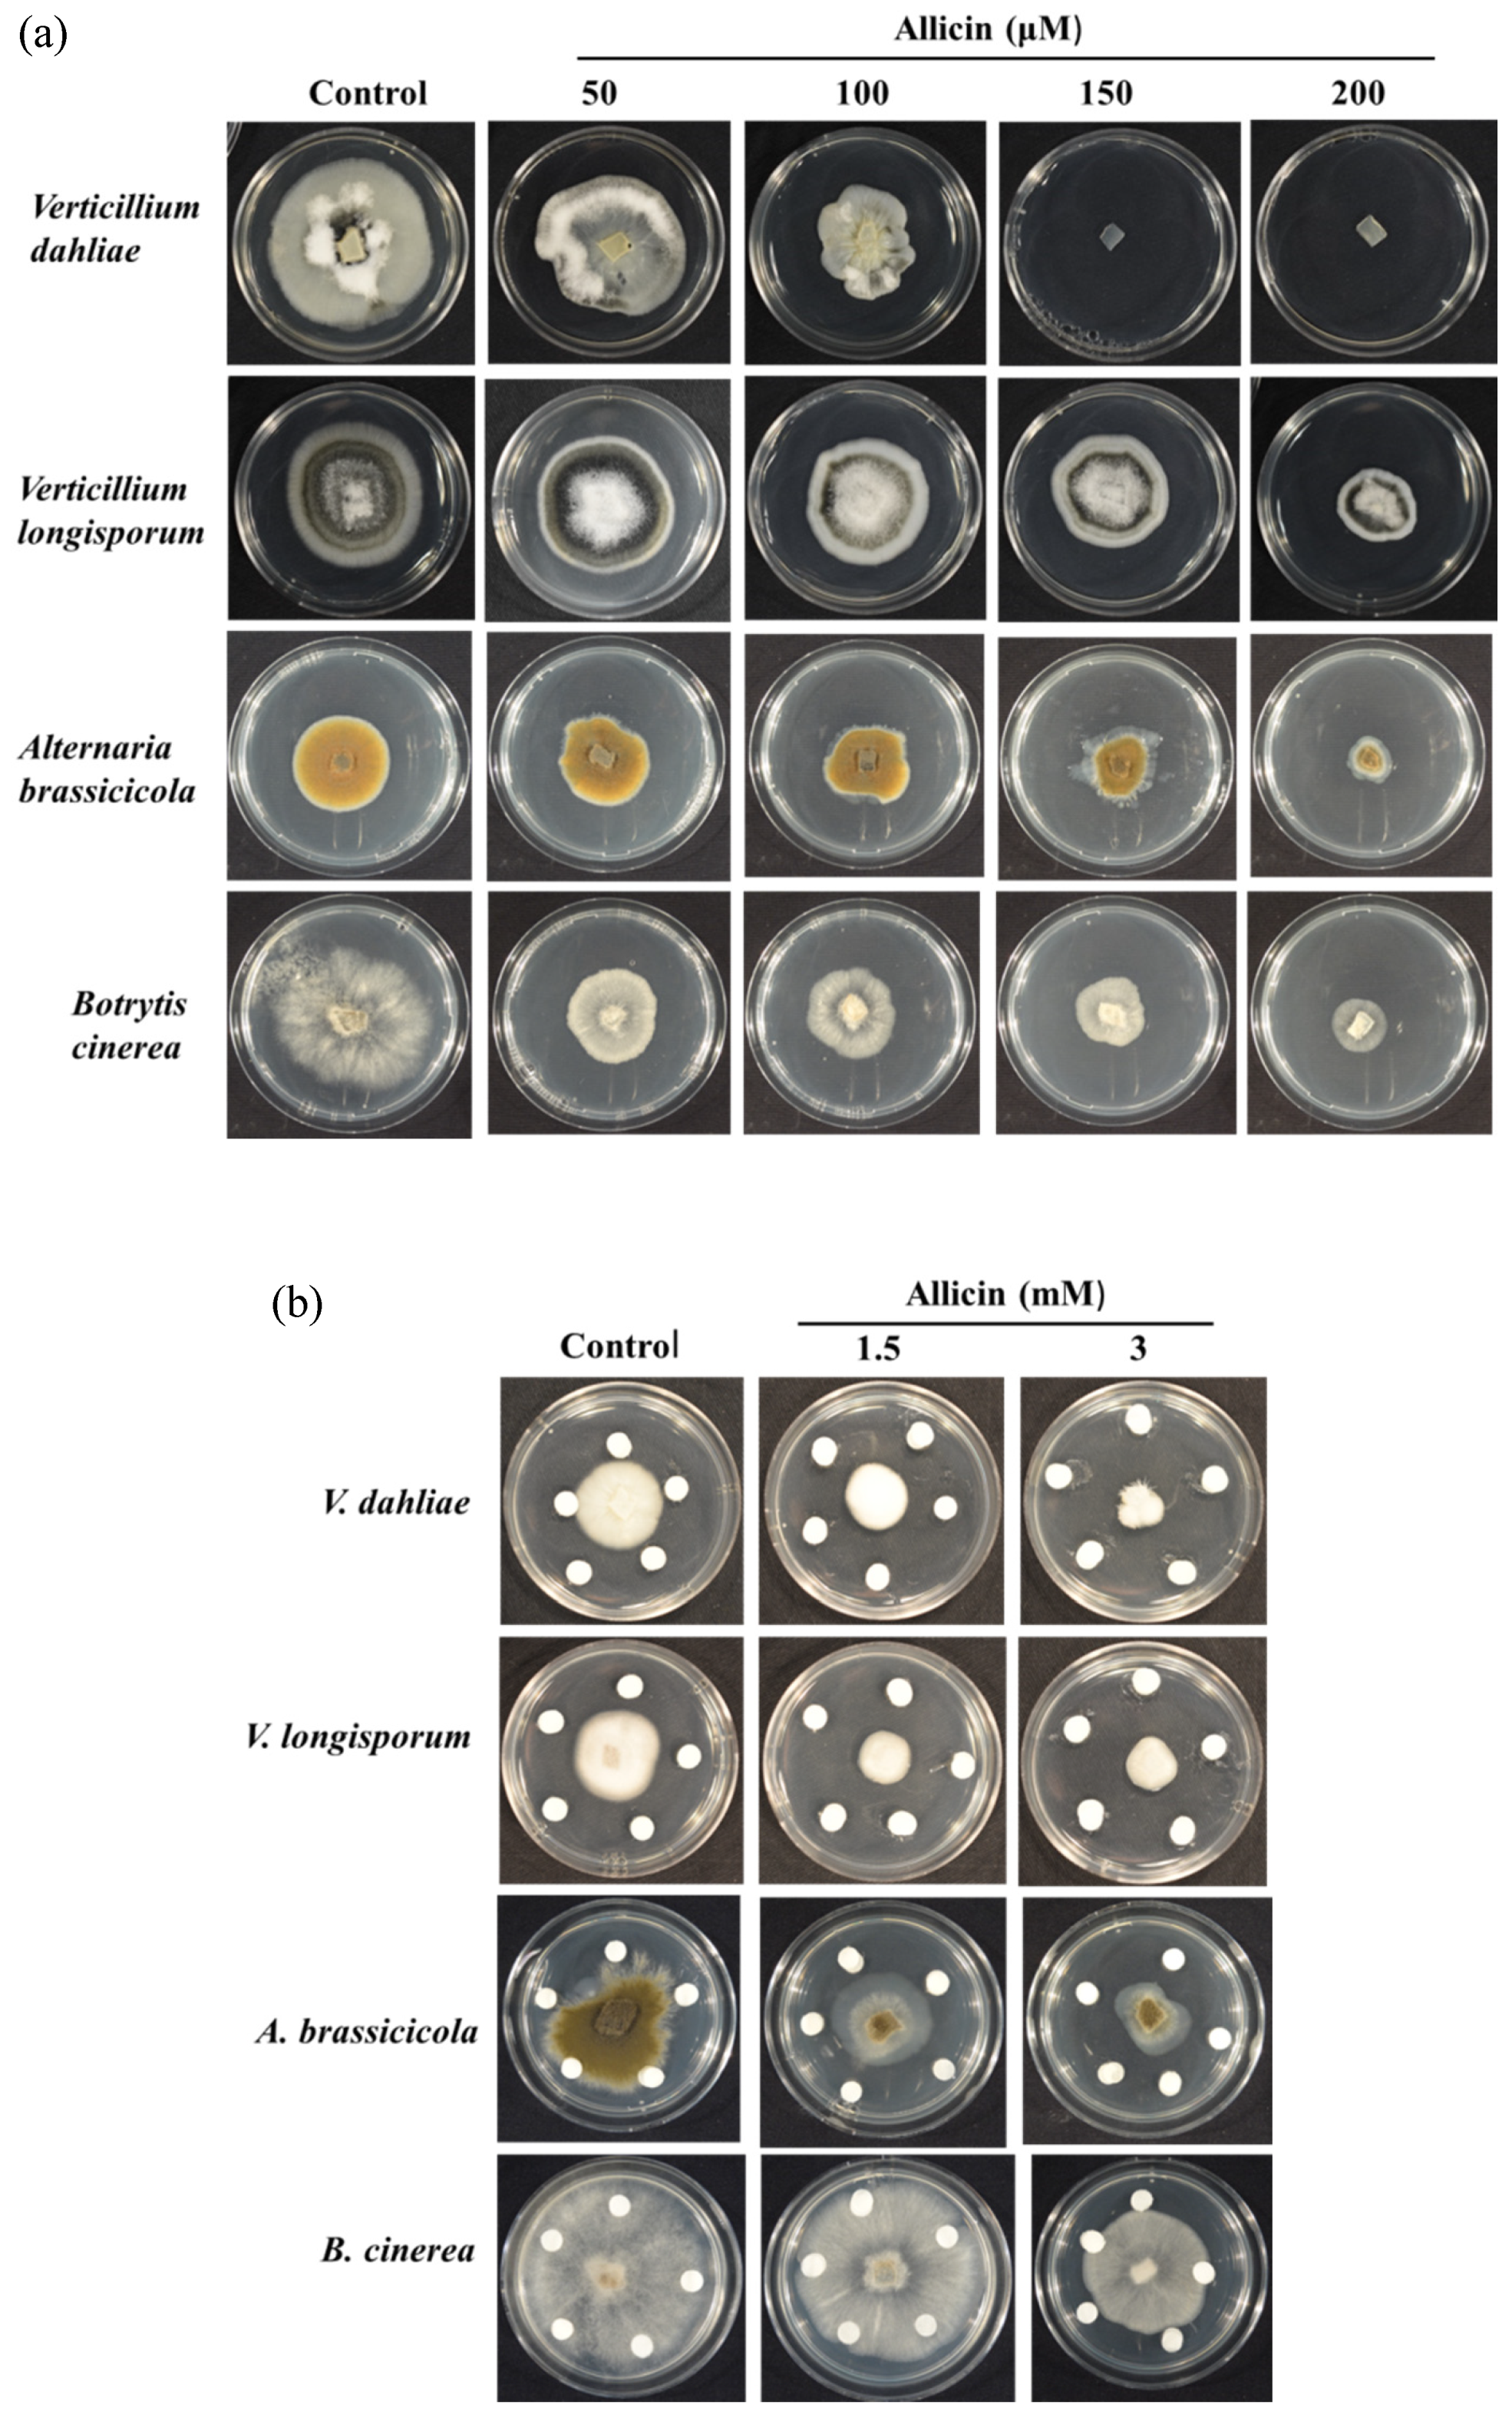
Applsci 10 02563 g002 Applsci 10 02563 g002

Abstract
Allicin (diallylthiosulfinate) is the principal organosulfur compound present in freshly damaged garlic tissue which exhibits a wide range of biological actions including antibacterial, antifungal, antiviral and anticancer properties. The antifungal activities of allicin were investigated against plant pathogenic fungi of agriculture importance. Furthermore, a yeast genome haploinsufficiency screening was also employed to decipher the antifungal mode of action of allicin. Wildtype and 1152 yeast mutant strains (each deprived of one specific allele of an essential gene in a diploid strain) were screened against allicin. Allicin exhibited promising antifungal properties against all the tested plant pathogens. Haploinsufficiency screening revealed three hypersensitive yeast mutants with gene deletions coding for proteins involved in DNA replication, mitochondrial translation and chromatids cohesion. These processes play a vital role in the cell cycle, growth and viability of yeast cells. Taken together, the results of the present study unravel the excellent antifungal activities and mechanisms and modes of action of allicin. These findings also indicate the potential use of allicin as an alternative “green” fungicide (fumigant) in agriculture.
1. Introduction
Garlic (Allium sativum L.) is an edible plant which has been employed extensively as a spice since ancient times. The potential antimicrobial activities of garlic constituents have been investigated for a long time. Louis Pasteur, for instance, investigated the antimicrobial potential of garlic. Organosulfur compounds, especially allicin, derived from garlic are excellent antimicrobial agents with a broad spectrum of biological activities against several bacteria (both Gram-positive and Gram-negative), fungi, protozoa and viruses [1,2,3,4,5]. Various studies have confirmed that thiol modification of glutathione and proteins is crucial for understanding the antimicrobial mode of action of allicin [6,7,8]. There are several mechanisms that contribute to the resistance to allicin in bacteria like the Mercuric reductase MerA proteins, which seem to be able to detoxify allicin by reduction. A genomic cluster conveying the resistance has been identified employing a highly allicin-resistant Pseudomonas fluorescens strain isolated from garlic [9]. Recently, allicin, because of its oxidizing nature, has been reported to induce apoptosis in yeast cells [8], an alternative cell-killing mechanism to the formerly suggested specific oxidative inactivation of crucial enzymes [10,11].
Allicin (diallylthiosulfinate) is released when garlic cloves are crushed, and alliin–an organosulfur precursor–is transformed into allicin via two step mechanism [8,12,13]. In the first step, alliin is converted to allylsulfenic acid and dehydroalanine by the enzyme alliinase. In the second step, allicin is synthesized from spontaneous condensation of two molecules of allylsulfenic acid to form one molecule of allicin (Figure 1) [14].

Figure 1.
Enzymatic transformation of alliin to allicin by the enzyme alliinase which involves the conversion of alliin to intermediates allylsulfenic acid and dehydroalanine, followed by the condensation of two molecules of allylsulfenic acid to yield allicin.
The antimicrobial and pharmacological activities of garlic extract are predominantly derived from allicin [15]. The antimicrobial potency of garlic is quite amazing: a 50 g of garlic bulb can yield approximately 100 mg of allicin [16]. As far as the antimicrobial properties of allicin are concerned, it has been reported that allicin inhibits more than 300 microorganisms [17], including a variety of bacteria, such as, Mycobacterium tuberculosis, Escherichia coli, Klebsiella proteus, Streptococcus spp., Staphylococcus spp., Bacillus spp., Helicobacter pylori and even methicillin-resistant, Staphylococcus aureus (MRSA) [15]. Similarly, the cytotoxicity of allicin in the form of vapors has also been evaluated in human lung pathogenic bacteria including multidrug resistant (MDR) bacterial strains [18]. The antimicrobial mode of action of allicin has been deciphered and DNA gyrase was confirmed to be the prime target of allicin in the antibacterial action [11].
Garlic extract has also shown promising antifungal activities against various pathogenic yeasts. The fungicidal activity of garlic was comparable to reference antimycotic drug, i.e., fluconazole [15,19]. Similarly, garlic extracts have been reported to inhibit the growth of pathogenic fungi, such as Botrytis cinerea, Penicillium expansum, Neofabraea alba, Fusarium and Rhizopus species [20,21]. The wide range of antifungal activities of allicin has also been confirmed against various plant-pathogenic fungi. Allicin exhibited promising antifungal activities both in vitro and in vivo against several plant-pathogenic fungi, e.g., Alternaria brassicicola, Botrytis cinerea, Magnaporthe grisea and Plectospherella cucumerina [22,23,24,25].
There is a severe antibiotic crisis owing to the emergence of resistance leading to inefficacy of the currently available antimicrobials. Therefore, the development of novel potent agrochemicals is an alternative to combat resistance developed by phytopathogens [25,26]. A large number of pests have developed resistance to the fungicides such as methyl bromide. This emerging problem of resistance leads to a considerable threat to the crop yield, especially in case of useful plants which are particularly threatened by fungi or which are difficult to implement in breeding methods in order to introduce resistance into the useful plant [25,26]. Allicin has gained considerable interest for the development of new fungicides for crop protection.
There are numerous pathogens that persist in the soil and invade the plants resulting in several diseases. The wilting pathogen, Verticillium, is particularly notorious and of increasing importance and threat [27,28]. The host spectrum of the genus Verticillium is broad [29], including economically important crops, such as potatoes and other Solanaceous plants, and large trees [30]. Treating a disease that has already broken out with fungicides is hardly possible due to the way the fungus lives in the xylem of the plant. The only promising method that has so far been effective in the control of Verticillium is soil disinfection with fumigants such as methyl bromide [31,32]. The use of methyl bromide, however, is banned in the most countries worldwide due to its high toxicity to the environment and humans [33,34]. The ban on methyl bromide utilization has initiated the search for new methods to control soil-borne pathogens, weed seeds and pests. Several chemical and nonchemical methods have been introduced to eradicate pests and plant pathogens. For instance, biofumigants, steam, biocontrol and crop rotation are some of the methods to control phytopathogens [35]. There are some attempts to apply green “biological” solutions such as the introduction of Brassicaceae plant residues [34,36]. The isothiocyanates, present in these plants, have an inhibiting effect on the spores of the Verticillium fungus that germinate in the soil. Since allicin is volatile and inhibits the fungal spores in their germination stage, it can be exploited as an effective alternative fungicide via fumigation [37]. Botrytis cinerea represents another example of a plant fungus which is a major pathogen of cultivated vegetables, fruits and flowers. This pathogen causes grey mold on more than 240 plant species leading to major economic losses [38]. Similarly, plant pathogens of the genus Alternaria cause damage to Cruciferous crops, including broccoli, cauliflower, mustard and turnip. Blight disease is one of the most common diseases caused by these pathogens, causing an average yield loss in the range of 32%–57% [39].
In previous studies, the antifungal activity of allicin has been explained by proposing a variety of mechanisms of action. However, the mechanisms and modes of action of allicin pertinent to its health benefits are not yet completely understood [40].
More than half a century ago, allicin was evident as an inhibitor of several thiol-possessing enzymes, and glutathione overturned the inhibitory effect of allicin, which simply elucidated the principle of a nonspecific mechanism of action of allicin that includes its covalent bonding with the thiol groups in enzymes [41]. With reference to previously described modes of action, another study confirmed the interaction of allicin with protein thiol groups and also reported the diffusion of allicin across lipid bilayers [40,42]. Allicin has been reported to result in the widespread S-thioallylation in the human Jurkat cell proteome. Moreover, allicin affected the essential cellular functions of specific targets including those for cancer therapy [10].
Recently, the crucial role of copper and zinc in the antifungal mode of action of allicin was revealed by a mini haploinsufficiency profiling (HIP) and homozygous profiling (HOP) assays [43]. Moreover, the antifungal mode of allicin’s action, i.e., global gene expression profiling, was exploited to unravel the activity of the iron ion transporter, the proteasome and amino acid control in S. cerevisiae [44]. Besides allicin’s activity against fungus, the antibacterial activity was investigated against S. typhimurium by means of radio labelled precursors which demonstrated the inhibitory effect of allicin [45].
The present study aims at the determination of the antifungal activities of allicin against plant pathogenic fungi. Chemogenetic screening was also carried out to provide a glimpse into the mechanism of action of allicin by exploiting a whole library of yeast mutants deficient in genes coding for specific protein function.
Chemogenetic profiling is an approach based on screening a library of yeast strains that are deleted for genes coding for specific proteins. This technique is used to identify the potential targets and modes of action of cytotoxic compounds [46,47].
2. Materials and Methods
2.1. Synthesis of Allicin
Allicin was synthesized as described previously in the literature [48].
2.2. Growth Media and Strains
2.2.1. PDB (Potato Dextrose Broth) and PDA (Potato Dextrose Agar) Media
PDB was employed as a growth medium for plant pathogenic fungi, Verticillium dahliae, Verticillium longisporum, Alternaria brassicicola and Botrytis cinerea. PDA was employed for fungal growth during the determination of the antifungal activities of allicin.
2.2.2. YPD (Yeast Peptone Dextrose) Growth Medium
The YPD growth medium consisted of 10 g/L Yeast extract (Duchefa Biochemie, Haarlem, The Netherlands); 20 g/L Peptone (Duchefa Biochemie, Haarlem, The Netherlands; 20 g/L Glucose (Duchefa Biochemie, Haarlem, The Netherlands); for the solid medium, 15 g/L Agar-Agar, Kobe 1(Carl-Roth, Karlsruhe, D) was added, and all the chemicals were mixed before autoclaving.
2.2.3. CSM (Complete Supplement Medium) Growth Medium
The CSM growth medium contained 6.9 g/L Yeast Nitrogen Base (Formedium, Norfolk, UK); 0.8 g/L Complete Supplement Mixture (CSM) Drop Out: Complete (Formedium, Norfolk, UK); 40 g/L Glucose (Duchefa Biochemie, Haarlem, The Netherlands); for the solid medium, 15 g/L Agar-Agar, Kobe 1(Carl-Roth, Karlsruhe, D) was added, and all the chemicals were mixed and autoclaved.
2.2.4. Fungal Strains
Plant pathogenic fungi, such as V. dahliae V. longisporum, A. brassicicola and B. cinerea were employed to investigate the antifungal activities of allicin.
2.2.5. Yeast Strains
The S. cerevisiae strains utilized in this study include BY4743 (BY4743 MATa/MATα his3Δ1/his3Δ1; leu2Δ0/leu2Δ0; met15Δ0/met15; lys2/lys2Δ0; ura3Δ0/ura3Δ0) and 1152 yeast mutants deleted for genes coding for specific protein functions (Euroscarf).
2.3. Assessment of Antifungal Activity
The antifungal activity of allicin was evaluated against V. dahliae, V. longisporum (natural isolates), A. brassicicola and B. cinerea by determining the effect of various concentrations of allicin on fungal growth utilizing the following assays.
2.3.1. Zone of Growth Assay
Allicin was added to liquid PDA to achieve the final concentrations of 50, 100, 150 and 200 μM. The PDA was then poured into Petri plate. After the solidification of the agar, a plug (of about 10 mm) of mycelium, cut from the freshly growing cultures of plant pathogenic fungi (V. dahliae, V. longisporum, A. brassicicola and B. cinerea), was inoculated in the center of Petri plate.
For second assay, a fungal suspension (50 μL) was added to the agar medium (5 mL) and then transferred to a Petri plate. After the solidification of the agar, a plug of fungal mycelium was placed at the center of a Petri plate containing the agar medium. Five paper discs were evenly distributed around the mycelium. Then, 20 μL of the required concentration (1.5 and 3 mM) of allicin was pipetted into each disc. Plates were then incubated at 22 °C for one week, and finally analyzed and photographed [24].
2.3.2. Inhibition Zone Assay
A spore suspension (100 μL) of the respective fungi was pipetted into a Falcon tube containing a 10 mL PDA medium and the agar was transferred immediately into Petri dish of a 9 cm diameter. This resulted in a homogenous distribution of fungal spores throughout the plate. Then, 20 μL of test compound (2, 4 and 8 mM) was pipetted onto the hole cut with the help of cork borer. Plates were then incubated at 22 °C, and the diameters of the inhibition zones surrounding the holes were determined [3,49].
2.3.3. Gas Phase Assay
Cultures of fungi were added into the PDA medium as described above. Then, 20 µL of allicin (80 mM) was pipetted at the center of the lid of the Petri dish. The plates were then inverted and incubated at a temperature of 22 °C. The plates were finally photographed after five days of the treatment [3].
2.4. Yeast Chemogenetic Screening
After investigating the antifungal activity of allicin, chemogenetic profiling was performed by employing wildtype yeast and mutants to decipher the antifungal mode of action of allicin.
Measuring Yeast Growth Kinetics
A library comprising of 1152 diploid knock-out yeast mutants was purchased from Euroscarf and re-arrayed into 96 well plates in 15% glycerol to produce a library of 14 plates which were then stored at −80 °C.
These mutants were then screened against allicin at a concentration of 50 μM. The effect of allicin on the growth kinetics of various yeast strains was determined as follows: different yeast mutants and wildtype cultures were grown overnight (50 mL YPD inoculated with a single colony in a 250 mL Erlenmeyer flask, shaken at 220 rpm and 28 °C). The resultant cultures were diluted to an OD600 of one (measured with a Spectrophotometer DU 530 by Beckman Coulter GmbH, Krefeld, D), and finally each culture was diluted to one in 25 mL of CSM broth. Then, 135 μL of diluted culture was pipetted into the wells of polystyrene flat base 96-well plate by using a 12-channels pipette. Allicin was introduced into each well to achieve final concentration of 50 μM. The untreated wells contained culture and medium for growth only. The plate was then shaken at 28 °C and the OD was measured at 600 nm continuously overnight employing a plate reader (Plate reader Tristar2 LB 942 Multimode Reader by Berthold Technologies GmbH & Co. KG, Bad Wildbad, D) [3].
3. Results and Discussion
3.1. Evaluation of Antifungal Activity of Allicin
Overall, the results obtained as part of this study indicate the remarkable antifungal activities of allicin against fungi. A strong concentration dependent growth inhibition of fungi was observed. These results will now be presented and discussed in more detail.
3.1.1. Determination of Zone of Growth
The zones of growth of fungi were determined at different concentrations (50, 100, 150 and 200 µM) of allicin. A strong concentration dependent inhibition of all target fungi was observed. The growth of fungal colonies reduced significantly as compared to the control at each concentration of allicin employed. The growth of V. dahliae was completely inhibited by allicin at a concentration of ≥150 µM. Similarly, the growth of B. cinerea and A. brassicicola was strongly inhibited at a concentration of 200 µM. In contrast, V. longisporum was least inhibited by allicin even at the highest concentration used (200 µM) (Figure 2a). These findings reveal the excellent antifungal potential of allicin at a 200 µM or lower concentration against model plant pathogens.

Figure 2.
Zones of growth of fungi after treatment with allicin at different concentrations. The fungal growth zone is greater in respective control as compared to plates containing specific concentration of allicin. (a) Allicin was added to PDA to achieve final concentrations of 50, 100, 150 and 200 μM. (b) The 20 µL of 1.5 or 3 mM allicin was pipetted into each disc. The plates were then incubated at 22 °C for one week and photographed. In the control plate, the fungus grew normally from center towards the corners of the plate. Fungal growth was restricted in allicin treated plates. The concentration dependent growth inhibition was observed in case of test fungi.
In the second assay, allicin was employed at concentrations of 1.5 and 3 mM to elucidate the potential antifungal activities. Allicin (1.5 or 3 mM) was added to the paper discs evenly distributed around the plug of mycelium. A concentration-dependent fungal growth inhibition was observed in allicin treated fungi. At a concentration of 1.5 mM, allicin resulted in a decrease in the growth of test fungi. A strong antifungal activity was observed at the highest concentration (3 mM), particularly in the cases of V. dahliae and V. longisporum (Figure 2b). These findings are in accordance with the previous investigations reporting the antifungal activity of allicin [15,20,21,22,50].
3.1.2. Inhibition Zone Assay
A special fungal-seeded agar was employed for this part of the investigation. The efficacy of this assay for assessing the antifungal activity of novel test compounds is described in the literature [49]. An adequate water solubility of the compound is a critical requirement for this method. It implies that the target substance must be able to diffuse through the water-based agar-solidified medium. Allicin treatment resulted in the inhibition of fungal growth even at the lowest concentration (2 mM). The efficacy of allicin varies in case of each fungal strain tested. There was clear zone for inhibition with sharp edges in case of A. brassicicola (Figure 3b). Nevertheless, a greater antifungal activity was observed for other fungi with no sharp boundaries for each concentration of allicin (Figure 3a). It infers that there was almost complete inhibition of fungal growth around the wells containing allicin. On the other hand, fungi grow predominantly in the area without allicin (control).

Figure 3.
Plate inhibition zone assay showing the antifungal activity of allicin against model fungi. Fungal cultures were incorporated into warm agar (50 °C) and poured into a Petri dish. (a) Representative pictures for fungi (V. dahliae, V. longisporum, A. brassicicola and B. cinerea). The lower well contained 20 µL of sterile water (Control). (b) The diameter of inhibition zone was measured for the hole containing 20 µL of 2, 4 and 8 mM solution of allicin against A. brassicicola. Error bars show standard deviation about the mean, n = 9. *** p < 0.001.
3.1.3. Gas Phase Assay
To investigate the antifungal activity of allicin via the gas phase, the 20 µL of allicin (80 mM) was placed at the center of a Petri dish lid and PDA containing fungal culture in the petri dish base was inverted over the lid. Thus, there was diffusion of allicin in the petri dish, without any contact between the allicin and the medium. Allicin produced an inhibition zone in the agar medium above the droplet in the Petri plate lid for all fungi tested. Interestingly, there was a complete growth inhibition for V. dahliae and B. cinerea. Moreover, in case of the other two fungi, V. longisporum and A. brassicicola, there was a clear zone of inhibition (greater zone of inhibition in case of V. longisporum (Figure 4). In this experiment, surprisingly, there are often clear zones of inhibition with fairly sharp borders. This can be interpreted as the concentration gradient of allicin diffusing away from the central drop of allicin into the air in the closed Petri dish, and a tight concentration threshold for the inhibition of fungi in the agar medium.

Figure 4.
Allicin shows antifungal activity via the gas phase. A 20 µL drop of an 80 mM solution of allicin was placed at the lid of a Petri dish and covered by the base with bacteria-seeded agar inverted over it. Thus, the agar did not come into contact with the droplet. Inhibition of growth was visible as an inhibition zone with reduced fungal growth. Control plates without allicin exhibit complete fungal growth. However, allicin-containing plates show growth inhibition.
The potential of allicin as a grain fumigant against three stored product pests has previously been investigated. The efficacy of allicin as a botanical fumigant was already reported [51]. Similarly, garlic juice containing allicin has also been evaluated against dipteran pests. The study has reported the insecticidal activity of garlic juice against the pests tested [52]. In another study, the components and oils from garlic were reported to exhibit remarkable insecticidal activity through fumigation [53,54]. The excellent antifungal activity of allicin via gas phase confirms the utilization of allicin as potential biofumigant. Moreover, garlic juice may be extracted directly from garlic and sprayed into fields to control soil-borne pathogens and pests.
3.2. Yeast Genome Haploinsufficiency Screening
Yeast chemogenetic profiling was carried out to elucidate the possible mechanisms of the fungicidal properties of allicin. The haploinsufficiency screening was performed by employing wildtype BY4743 and 1152 yeast deletion strains independently by employing 50 μM allicin.
The mutants and wildtype were tested by measuring the growth curves overnight with and without allicin. This screening resulted in the hypersensitivity of three yeast mutant strains as compared to the wildtype.
Quantitative Identification of Hypersensitive Strains
According to previous studies, it is required to make a comparison of treated and untreated growth profiles as many heterozygous mutants grow slowly in rich culture medium (Giaever et al., 1999). In the present investigation, mutants such as Δnpa3, Δmcm5 and Δhts1 were recognized as hypersensitive in comparison to the untreated strains. Moreover, these mutants exhibited lower growth compared to wildtype in the allicin-treated samples (Figure 5).

Figure 5.
Effects of allicin (50 μM) on the growth of wildtype BY4743 and Δnpa3, Δmcm5 and Δhts1 mutants in CSM (complete supplement medium). The red line in each graph represents the untreated (culture in CSM only) and blue line shows the treatment with 50 μM of allicin. There is greater difference between treated and untreated in case of hypersensitive yeast mutants as compared to BY4743. The experiments were repeated twice with similar results. Error bars show standard deviation about the mean.
Figure 6 represents the endpoint values of treated wildtype and hypersensitive mutants after 15 h of treatment. It shows that there was greater inhibition of growth of mutants related to the wildtype after treatment with 50 μM of allicin.

Figure 6.
Graph showing the effects of 50 μM of allicin after 15 h on the growth of wildtype BY4743 and Δnpa3, Δmcm5 and Δhts1 mutants in CSM. Values represent mean ± S.D. *** p < 0.001.
The hypersensitivity of yeast to allicin was explored by screening wildtype and yeast mutants against allicin. Drug targets can be uncovered by hypersensitivity to a drug of a heterozygous deletion strain containing one copy of a gene as compared to a wildtype strain containing two copies. HIP probes heterozygous strains, while most of the genetic screens examine the phenotypic results of a complete gene deletion in the homozygous strains. Thus, HIP is advantageous as compared to HOP because, with complete deletions, it is difficult to determine the primary effect of the compound and impossible to detect the effect of any essential gene [47]. Yeast haploinsufficiency screening has been widely employed to decipher the mechanisms and modes of action of compounds exhibiting antifungal activities, as for example, the determination of MOA of saponin, α-hederin, from ivy leaves (Hedera helix) by haploinsufficiency profiling (HIP) [55]. This saponin exhibits activity against Candida albicans and its antifungal MOA was similar to that of the known calcineurin inhibitor FK506 [56]. During chemogenetic screening, various yeast deletion strains lacking specific genes were employed and toxicity was observed in the presence of the drug with reference to the wildtype. The mutants that are hypersensitive to drugs compared to the wildtype may give clue about the possible relationship between the drug and the gene for a specific protein/enzyme absent in the mutant and its role in metabolism or defense. This technique is simple, easy and presents a robust avenue for the cost-effective and prompt screening of numerous compounds in order to identify the possible targets and modes of action of cytotoxic compounds [57].
Table 1 represents the biological/ molecular functions of the hypersensitive mutants are presented. Figure 5 shows growth curves for the treated and untreated wildtype and mutant strains with allicin that inhibited the growth of three yeast mutant strains mainly related to chromatid cohesion, double-strand break repair and mitochondrial translation. Each yeast mutant is inhibited to a greater extent as compared to the wildtype strain. The yeast strain Δmcm5, which expresses the reduced level of double-strand repair via break-induced replication, was found to be the most sensitive strain to allicin, and the corresponding MCM5p protein, along with other MCMp proteins, is essential for DNA replication [58]. The second hypersensitive mutant was Δnpa3, which carries deletion for mitotic sister chromatid cohesion. Sister chromatid cohesion and separation is essential for DNA double-strand break repair and replication [59]. The third one was Δhts1, the mutant with gene deleted for mitochondrial translation. The respective HTS1 gene encodes mitochondrial synthetases and the mutations in the HTS1 gene may result in lethality [60]. Allicin has been reported to cause mitochondrial dysfunction leading to cell necrosis and apoptosis in Leshmenia [61]. Previously, allicin treatment resulted in the inhibition of bacterial cell growth by inhibiting DNA, RNA and protein synthesis [45]. One study has demonstrated the action of allicin on several different yeast transcription factors [44]. Allicin also affected the signal transduction and resulted in the apoptosis [62]. Similarly, allicin inhibited the proliferation and induced apoptosis of various cancers by DNA fragmentation and activation of caspases and poly (ADP-ribose) polymerase cleavage [63,64]. Garlic extracts and allicin have been reported to inhibit the cholesterol synthesis in mammalian cells [65,66,67]. Moreover, allicin caused the lowering of cholesterol in hypercholesterol- emic mice [68,69]. Allicin has also been shown to induce cell cycle arrest of gastric cancer cells in the M phase [70]. In addition, allicin induced cell cycle arrest, particularly in the G2/M phase [71]. It has also been confirmed that allicin induces apoptosis in yeast [8] and in mammalian cells [72]. Thus, allicin resulted in the growth inhibition of mutants with specific deletions for genes coding for vital proteins, required for important cellular processes, i.e., cell viability and growth. These findings require further investigations to find out the sole mechanism responsible for the antimicrobial activities of allicin.

Table 1.
Hypersensitive mutants following allicin treatment.
4. Conclusions
In summary, the current investigation uncovers the potential antifungal activities of allicin against a variety of pathogenic fungi. The main aim of the study was to exploit allicin as a potential antifungal agent against a broad spectrum of plant pathogens. The antifungal activity of allicin was explored by employing different kinds of assays. Finally, yeast chemogenetic profiling was carried out to explore the underlying mechanisms of the pronounced toxicity of allicin against plant pathogens. Allicin showed promising antifungal activities against these pathogens. The excellent activity of allicin via gas phase signifies the potential applications of this substance in the field of agriculture. The screening of allicin against yeast mutants resulted in the greater growth inhibition of three mutants (Δnpa3, Δmcm5 and Δhts1) as compared to the untreated controls. Moreover, these mutants showed hypersensitivity to allicin in comparison to the wildtype yeast. These yeast mutants lack genes coding for proteins involved in DNA replication, chromatids cohesion and mitochondrial translation. These processes are critical for yeast cell growth and vitality. These findings indicate the possible targets of allicin in the antifungal activity. Further studies are obviously needed to explore the additional targets of allicin responsible for the antimicrobial and cytotoxic actions of this substance.
Author Contributions
C.J. and M.C.H.G.; conceived the study. M.S.; performed the experiments and analyzed the data. M.S.; M.C.H.G.; M.J.N. and C.J. wrote the manuscript. All authors have read and agreed to the published version of the manuscript.
Funding
The authors acknowledge Landgard Stiftung for support and Deutscher Akademischer Austauschdienst (DAAD) Scholarship Scheme (57202887).
Acknowledgments
Alan J. Slusarenko, Jan Borlinghaus, Jana Reiter, Ulrike Noll and Bianka Reiss are acknowledged for advice, discussions and proof-reading of the manuscript.
Conflicts of Interest
The authors declare no conflict of interest.
References
- Adler, B.B.; Beuchat, L.R. Death of Salmonella, Escherichia coli O157:H7, and Listeria monocytogenes in garlic butter as affected by storage temperature. J. Food Prot. 2002, 65, 1976–1980. [Google Scholar] [CrossRef] [PubMed]
- O’Gara, E.A.; Hill, D.J.; Maslin, D.J. Activities of garlic oil, garlic powder, and their diallyl constituents against Helicobacter pylori. Appl. Environ. Microbiol. 2000, 66, 2269–2273. [Google Scholar] [CrossRef] [PubMed]
- Leontiev, R.; Hohaus, N.; Jacob, C.; Gruhlke, M.C.H.; Slusarenko, A.J. A Comparison of the Antibacterial and Antifungal Activities of Thiosulfinate Analogues of Allicin. Sci. Rep. 2018, 8, 6763. [Google Scholar] [CrossRef] [PubMed]
- Lemar, K.M.; Turner, M.P.; Lloyd, D. Garlic (Allium sativum) as an anti-Candida agent: A comparison of the efficacy of fresh garlic and freeze-dried extracts. J. Appl. Microbiol. 2002, 93, 398–405. [Google Scholar] [CrossRef] [PubMed]
- Weber, N.D.; Andersen, D.O.; North, J.A.; Murray, B.K.; Lawson, L.D.; Hughes, B.G. In vitro virucidal effects of Allium sativum (garlic) extract and compounds. Planta Med. 1992, 58, 417–423. [Google Scholar] [CrossRef] [PubMed]
- Loi, V.V.; Huyen, N.T.T.; Busche, T.; Tung, Q.N.; Gruhlke, M.C.H.; Kalinowski, J.; Bernhardt, J.; Slusarenko, A.J.; Antelmann, H. Staphylococcus aureus responds to allicin by global S-thioallylation—Role of the Brx/BSH/YpdA pathway and the disulfide reductase MerA to overcome allicin stress. Free Radic. Biol. Med. 2019, 139, 55–69. [Google Scholar] [CrossRef]
- Horn, T.; Bettray, W.; Slusarenko, J.A.; Gruhlke, C.M. S-allylmercaptoglutathione is a Substrate for Glutathione Reductase (E.C. 1.8.1.7) from Yeast (Saccharomyces cerevisiae). Antioxidants 2018, 7, 86. [Google Scholar] [CrossRef]
- Gruhlke, M.C.H.; Portz, D.; Stitz, M.; Anwar, A.; Schneider, T.; Jacob, C.; Schlaich, N.L.; Slusarenko, A.J. Allicin disrupts the cell’s electrochemical potential and induces apoptosis in yeast. Free Rad. Biol. Med. 2010, 49, 1916–1924. [Google Scholar] [CrossRef]
- Borlinghaus, J.; Bolger, A.; Schier, C.; Vogel, A.; Usadel, B.; Gruhlke, M.C.H.; Slusarenko, A.J. Genetic and molecular characterization of multicomponent resistance of Pseudomonas against allicin. Life Sci. 2020, 3. [Google Scholar] [CrossRef]
- Gruhlke, M.C.H.; Antelmann, H.; Bernhardt, J.; Kloubert, V.; Rink, L.; Slusarenko, A.J. The human allicin-proteome: S-thioallylation of proteins by the garlic defence substance allicin and its biological effects. Free Radic. Biol. Med. 2019, 131, 144–153. [Google Scholar] [CrossRef]
- Reiter, J.; Hubbers, A.M.; Albrecht, F.; Leichert, L.I.O.; Slusarenko, A.J. Allicin, a natural antimicrobial defence substance from garlic, inhibits DNA gyrase activity in bacteria. Int. J. Med. Microbiol. 2020, 310, 151359. [Google Scholar] [CrossRef] [PubMed]
- Stoll, A.; Seebeck, E. Chemical investigations on alliin, the specific principle of garlic. Adv. Enzymol. Relat. Subj. Biochem. 1951, 11, 377–400. [Google Scholar] [PubMed]
- Kuettner, E.B.; Hilgenfeld, R.; Weiss, M.S. The active principle of garlic at atomic resolution. J. Biol. Chem. 2002, 277, 46402–46407. [Google Scholar] [CrossRef]
- Borlinghaus, J.; Albrecht, F.; Gruhlke, M.C.; Nwachukwu, I.D.; Slusarenko, A.J. Allicin: Chemistry and biological properties. Molecules 2014, 19, 12591–12618. [Google Scholar] [CrossRef] [PubMed]
- Ankri, S.; Mirelman, D. Antimicrobial properties of allicin from garlic. Microbes Infect 1999, 1, 125–129. [Google Scholar] [CrossRef]
- Slusarenko, A.J.; Patel, A.; Portz, D. Control of plant diseases by natural products: Allicin from garlic as a case study. Eur. J. Plant Pathol. 2008, 121, 313–322. [Google Scholar] [CrossRef]
- Fujisawa, H.; Watanabe, K.; Suma, K.; Origuchi, K.; Matsufuji, H.; Seki, T.; Ariga, T. Antibacterial potential of garlic-derived allicin and its cancellation by sulfhydryl compounds. Biosci. Biotechnol. Biochem. 2009, 73, 1948–1955. [Google Scholar] [CrossRef]
- Reiter, J.; Levina, N.; van der Linden, M.; Gruhlke, M.; Martin, C.; Slusarenko, A.J. Diallylthiosulfinate (Allicin), a Volatile Antimicrobial from Garlic (Allium sativum), Kills Human Lung Pathogenic Bacteria, Including MDR Strains, as a Vapor. Molecules 2017, 22, 1711. [Google Scholar] [CrossRef]
- Khodavandi, A.; Alizadeh, F.; Harmal, N.S.; Sidik, S.M.; Othman, F.; Sekawi, Z.; Jahromi, M.A.; Ng, K.P.; Chong, P.P. Comparison between efficacy of allicin and fluconazole against Candida albicans in vitro and in a systemic candidiasis mouse model. Fems Microbiol. Lett. 2011, 315, 87–93. [Google Scholar] [CrossRef]
- Daniel, C.K.; Lennox, C.L.; Vries, F.A. IN-Vitro Effects OF Garlic Extracts On Pathogenic Fungi Botrytis Cinerea, Penicillium Expansum And Neofabraea Alba. S. Afr. J. Sci. 2015, 111, 1–8. [Google Scholar] [CrossRef]
- Kutawa, A.; Danladi, M.; Haruna, A. Antifungal Activity of Garlic (Allium sativum) Extract on Some Selected Fungi. J. Med. Herbs Ethnomed. 2018, 4, 12–14. [Google Scholar]
- Curtis, H.; Noll, U.; Störmann, J.; Slusarenko, A.J. Broad-spectrum activity of the volatile phytoanticipin allicin in extracts of garlic (Allium sativum L.) against plant pathogenic bacteria, fungi and Oomycetes. Physiol. Mol. Plant Pathol. 2004, 65, 79–89. [Google Scholar] [CrossRef]
- Perello, A.; Gruhlke, M.C.; Slusarenko, A.J. Effect of garlic extract on seed germination, seedling health, and vigour of pathogen-infested wheat. J. Plant Prot. Res. 2013, 53, 317–323. [Google Scholar] [CrossRef]
- Perelló, A.; Noll, U.; Slusarenko, A.J. In vitro efficacy of garlic extract to control fungal pathogens of wheat. J. Med. Plant Res. 2013, 7, 1809–1817. [Google Scholar]
- Hahn, M. The rising threat of fungicide resistance in plant pathogenic fungi: Botrytis as a case study. J. Chem. Biol. 2014, 7, 133–141. [Google Scholar] [CrossRef]
- Hobbelen, P.H.; Paveley, N.D.; van den Bosch, F. The emergence of resistance to fungicides. PLoS ONE 2014, 9, e91910. [Google Scholar] [CrossRef]
- Barbara, D.J.; Clewes, E. Plant pathogenic Verticillium species: How many of them are there? Mol. Plant Pathol. 2003, 4, 297–305. [Google Scholar] [CrossRef]
- Daayf, F. Verticillium wilts in crop plants: Pathogen invasion and host defence responses. Can. J. Plant Pathol. 2014, 37, 8–20. [Google Scholar] [CrossRef]
- Bhat, R.G.; Subbarao, K.V. Host Range Specificity in Verticillium dahliae. Phytopathology 1999, 89, 1218–1225. [Google Scholar] [CrossRef]
- Keykhasaber, M.; Thomma, B.P.H.J.; Hiemstra, J.A. Verticillium wilt caused by Verticillium dahliae in woody plants with emphasis on olive and shade trees. Eur. J. Plant Pathol. 2018, 150, 21–37. [Google Scholar] [CrossRef]
- Goicoechea, N. To what extent are soil amendments useful to control Verticillium wilt? Pest Manag. Sci. 2009, 65, 831–839. [Google Scholar] [CrossRef]
- Short, D.P.; Sandoya, G.; Vallad, G.E.; Koike, S.T.; Xiao, C.L.; Wu, B.M.; Gurung, S.; Hayes, R.J.; Subbarao, K.V. Dynamics of verticillium species microsclerotia in field soils in response to fumigation, cropping patterns, and flooding. Phytopathology 2015, 105, 638–645. [Google Scholar] [CrossRef] [PubMed]
- Van Den Oever, R.U.; Roosels, D.; Lahaye, D. Actual hazard of methyl bromide fumigation in soil disinfection. Br. J. Ind. Med. 1982, 39, 140–144. [Google Scholar] [CrossRef][Green Version]
- Olivier, C.; Vaughn, S.F.; Mizubuti, E.S.G.; Loria, R. Variation in Allyl Isothiocyanate Production Within Brassica Species and Correlation with Fungicidal Activity. J. Chem. Ecol. 1999, 25, 2687–2701. [Google Scholar] [CrossRef]
- Porter, I.J.; Brett, R.W.; Wiseman, B.M. Alternatives to methyl bromide: Chemical fumigants or integrated pest management systems? Australas. Plant Pathol. 1999, 28, 65–71. [Google Scholar] [CrossRef]
- Neubauer, C.; Heitmann, B.; Müller, C. Biofumigation potential of Brassicaceae cultivars to Verticillium dahliae. Eur. J. Plant Pathol. 2014, 140, 341–352. [Google Scholar] [CrossRef]
- Auger, J.; Arnault, I.; Diwo-Allain, S.; Ravier, M.l.; Molia, F.; Pettiti, M. Insecticidal and fungicidal potential of Allium substances as biofumigants. Agroindustria 2004, 3, 5–8. [Google Scholar]
- Dean, R.; Van Kan, J.A.; Pretorius, Z.A.; Hammond-Kosack, K.E.; Di Pietro, A.; Spanu, P.D.; Rudd, J.J.; Dickman, M.; Kahmann, R.; Ellis, J.; et al. The Top 10 fungal pathogens in molecular plant pathology. Mol. Plant Pathol. 2012, 13, 414–430. [Google Scholar] [CrossRef]
- Mamgain, A.; Roychowdhury, R.; Tah, J. Alternaria pathogenicity and its strategic controls. Res. J. Biol. 2013, 1, 1–9. [Google Scholar]
- Rabinkov, A.; Miron, T.; Konstantinovski, L.; Wilchek, M.; Mirelman, D.; Weiner, L. The mode of action of allicin: Trapping of radicals and interaction with thiol containing proteins. Biochim. Biophys. Acta 1998, 1379, 233–244. [Google Scholar] [CrossRef]
- Wills, E.D. Enzyme Inhibition by Allicin, the Active Principle of Garlic. Biochem. J. 1956, 63, 514–520. [Google Scholar] [CrossRef] [PubMed]
- Miron, T.; Rabinkov, A.; Mirelman, D.; Wilchek, M.; Weiner, L. The mode of action of allicin: Its ready permeability throughphospholipid membranes may contribute to its biological activity. Biochim. Et Biophys. Acta 2000, 1463, 20–30. [Google Scholar] [CrossRef]
- Prescott, T.A.K.; Panaretou, B. A Mini HIP HOP Assay Uncovers a Central Role for Copper and Zinc in the Antifungal Mode of Action of Allicin. J. Agric. Food Chem. 2017, 65, 3659–3664. [Google Scholar] [CrossRef]
- Yu, L.; Guo, N.; Meng, R.; Liu, B.; Tang, X.; Jin, J.; Cui, Y.; Deng, X. Allicin-induced global gene expression profile of Saccharomyces cerevisiae. Appl. Microbiol. Biotechnol. 2010, 88, 219–229. [Google Scholar] [CrossRef] [PubMed]
- Feldberg, R.S.; Chang, S.C.; Kotik, A.N.; Nadler, M.; Neuwirth, Z.; Sundstrom, D.C.; Thompson, N.H. In vitro mechanism of inhibition of bacterial cell growth by allicin. Antimicrob. Agents Chemother. 1988, 32, 1763–1768. [Google Scholar] [CrossRef]
- Giaever, G.; Shoemaker, D.D.; Jones, T.W.; Liang, H.; Winzeler, E.A.; Astromoff, A.; Davis, R.W. Genomic profiling of drug sensitivities via induced haploinsufficiency. Nat. Genet. 1999, 21, 278–283. [Google Scholar] [CrossRef]
- Giaever, G.; Flaherty, P.; Kumm, J.; Proctor, M.; Nislow, C.; Jaramillo, D.F.; Chu, A.M.; Jordan, M.I.; Arkin, A.P.; Davis, R.W. Chemogenomic profiling: Identifying the functional interactions of small molecules in yeast. Proc. Natl. Acad. Sci. USA 2004, 101, 793–798. [Google Scholar] [CrossRef]
- Albrecht, F.; Leontiev, R.; Jacob, C.; Slusarenko, A.J. An Optimized Facile Procedure to Synthesize and Purify Allicin. Molecules 2017, 22, 770. [Google Scholar] [CrossRef]
- Leontiev, R.; Slusarenko, A.J. Finding the Starting Point for Mode-of-Action Studies of Novel Selenium Compounds: Yeast as a Genetic Toolkit. Curr. Org. Synth. 2017, 14, 1–7. [Google Scholar] [CrossRef]
- Portz, D.; Koch, E.; Slusarenko, A.J. Effects of garlic (Allium sativum) juice containing allicin on Phytophthora infestans and downy mildew of cucumber caused by Pseudoperonospora cubensis. Eur. J. Plant Pathol. 2008, 122, 197–206. [Google Scholar] [CrossRef]
- Lu, Y.; Zhong, J.; Wang, Z.; Liu, F.; Wan, Z. Fumigation toxicity of allicin against three stored product pests. J. Stored Prod. Res. 2013, 55, 48–54. [Google Scholar] [CrossRef]
- Prowse, G.M.; Galloway, T.S.; Foggo, A. Insecticidal activity of garlic juice in two dipteran pests. Agric. For. Entomol. 2006, 8, 1–6. [Google Scholar] [CrossRef]
- Park, I.K.; Shin, S.C. Fumigant activity of plant essential oils and components from garlic (Allium sativum) and clove bud (Eugenia caryophyllata) oils against the Japanese termite (Reticulitermes speratus Kolbe). J. Agric. Food Chem. 2005, 53, 4388–4392. [Google Scholar] [CrossRef] [PubMed]
- Park, I.K.; Choi, K.S.; Kim, D.H.; Choi, I.H.; Kim, L.S.; Bak, W.C.; Choi, J.W.; Shin, S.C. Fumigant activity of plant essential oils and components from horseradish (Armoracia rusticana), anise (Pimpinella anisum) and garlic (Allium sativum) oils against Lycoriella ingenua (Diptera: Sciaridae). Pest Manag. Sci. 2006, 62, 723–728. [Google Scholar] [CrossRef]
- Prescott, T.A.; Rigby, L.P.; Veitch, N.C.; Simmonds, M.S. The haploinsufficiency profile of alpha-hederin suggests a caspofungin-like antifungal mode of action. Phytochemistry 2014, 101, 116–120. [Google Scholar] [CrossRef]
- Prescott, T.A.K.; Panaretou, B.; Veitch, N.C.; Simmonds, M.S.J. A yeast chemical genetics approach identifies the compound 3,4,5-trimethoxybenzyl isothiocyanate as a calcineurin inhibitor. Febs Lett. 2014, 588, 455–458. [Google Scholar] [CrossRef]
- Manikova, D.; Letavayova, L.M.; Vlasakova, D.; Kosik, P.; Estevam, E.C.; Nasim, M.J.; Gruhlke, M.; Slusarenko, A.; Burkholz, T.; Jacob, C.; et al. Intracellular diagnostics: Hunting for the mode of action of redox-modulating selenium compounds in selected model systems. Molecules 2014, 19, 12258–12279. [Google Scholar] [CrossRef]
- Snyder, M.; He, W.; Zhang, J.J. The DNA replication factor MCM5 is essential for Stat1-mediated transcriptional activation. Proc. Natl. Acad. Sci. USA 2005, 102, 14539–14544. [Google Scholar] [CrossRef]
- Alonso, B.; Chaussinand, G.; Armengaud, J.; Godon, C. A role for GPN-loop GTPase yGPN1 in sister chromatid cohesion. Cell Cycle 2011, 10, 1828–1837. [Google Scholar] [CrossRef]
- Chiu, M.I.; Mason, T.L.; Fink, G.R. Hts1 Encodes Both the Cytoplasmic and Mitochondrial Histidyl-Trna Synthetase of Saccharomyces Cerevisiae: Mutations Alter the Specificity of Compartmentation. Genetics 1992, 132, 987–1001. [Google Scholar]
- Corral, M.J.; Benito-Pena, E.; Jimenez-Anton, M.D.; Cuevas, L.; Moreno-Bondi, M.C.; Alunda, J.M. Allicin Induces Calcium and Mitochondrial Dysregulation Causing Necrotic Death in Leishmania. PLoS Negl. Trop. Dis. 2016, 10, e0004525. [Google Scholar] [CrossRef] [PubMed]
- Zheng, S.; Yang, H.; Zhang, S.; Wang, X.; Yu, L.; Lu, J.; Li, J. Initial study on naturally occurring products from traditional Chinese herbs and vegetables for chemoprevention. J. Cell. Biochem. Suppl. 1997, 27, 106–112. [Google Scholar] [CrossRef]
- Hassan, H.T. Ajoene (natural garlic compound): A new anti-leukaemia agent for AML therapy. Leuk. Res. 2004, 28, 667–671. [Google Scholar] [CrossRef] [PubMed]
- Park, S.Y.; Cho, S.J.; Kwon, H.C.; Lee, K.R.; Rhee, D.K.; Pyo, S. Caspase-independent cell death by allicin in human epithelial carcinoma cells: Involvement of PKA. Cancer Lett. 2005, 224, 123–132. [Google Scholar] [CrossRef] [PubMed]
- Sendl, A.; Schliack, M.; Loser, R.; Stanislaus, F.; Wagner, H. Inhibition of cholesterol synthesis in vitro by extracts and isolated compounds prepared from garlic and wild garlic. Atherosclerosis 1992, 94, 79–85. [Google Scholar] [CrossRef]
- Gebhardt, R.; Beck, H.; Wagner, K.G. Inhibition of cholesterol biosynthesis by allicin and ajoene in rat hepatocytes and HepG2 cells. Biochim. Biophys. Acta 1994, 1213, 57–62. [Google Scholar] [CrossRef]
- Stevinson, C.; Pittler, M.H.; Ernst, E. Garlic for treating hypercholesterolemia. A meta-analysis of randomized clinical trials. Ann. Intern. Med. 2000, 133, 420–429. [Google Scholar] [CrossRef]
- Yeh, Y.Y.; Liu, L. Cholesterol-lowering effect of garlic extracts and organosulfur compounds: Human and animal studies. J. Nutr. 2001, 131, 989S–993S. [Google Scholar] [CrossRef]
- Lu, Y.; He, Z.; Shen, X.; Xu, X.; Fan, J.; Wu, S.; Zhang, D. Cholesterol-lowering effect of allicin on hypercholesterolemic ICR mice. Oxidative Med. Cell. Longev. 2012, 2012, 489690. [Google Scholar] [CrossRef]
- Ha, M.W.; Yuan, Y. Allicin induced cell cycle arrest in human gastric cancer cell lines. Zhonghua Zhong Liu Za Zhi Chin. J. Oncol. 2004, 26, 585–589. [Google Scholar]
- Iciek, M.; Kwiecien, I.; Wlodek, L. Biological properties of garlic and garlic-derived organosulfur compounds. Environ. Mol. Mutagenesis 2009, 50, 247–265. [Google Scholar] [CrossRef] [PubMed]
- Gruhlke, M.C.; Nicco, C.; Batteux, F.; Slusarenko, A.J. The Effects of Allicin, a Reactive Sulfur Species from Garlic, on a Selection of Mammalian Cell Lines. Antioxidants 2016, 6, 1. [Google Scholar] [CrossRef] [PubMed]
© 2020 by the authors. Licensee MDPI, Basel, Switzerland. This article is an open access article distributed under the terms and conditions of the Creative Commons Attribution (CC BY) license (http://creativecommons.org/licenses/by/4.0/).